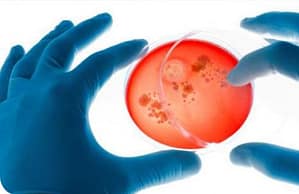

Bacteriuria asintomática
La bacteriuria asintomática (BA) es la presencia de un número específico de bacterias, que se estratifica según género ó presencia de dispositivo en una muestra de orina correctamente recogida, en una persona sin síntomas atribuibles a una infección urinaria.
Fuente: Consenso Argentino Intersociedades para el Manejo de la Infección del Tracto Urinario – Parte III
Intersociety Argentinean Consensus for Management of the Urinary Tract Infection -Part III
Sociedades Participantes: Sociedad Argentina de Infectología (SADI); Sociedad Argentina de Urología (SAU); Sociedad Argentina de Medicina (SAM); Sociedad Argentina de Bacteriología Clínica (SADEBAC); Sociedad de Ginecología y Obstetricia de Buenos Aires (SOGIBA)
Autores del Consenso: Coordinador: Gabriel Levy Hara1 (SADI); Secretario: Gustavo Lopardo2 (SADI)
Participantes:
SADI: María José López Furst3, Liliana Clara4, Daniel Pryluka5, Javier Desse6, Liliana Vázquez7, Gabriela Saravia8, Joaquín Bermejo 9, Jorge Gentile10, Sergio Prieto11, Beatriz Ricci12 y Alicia Lizzi13.
SAU: Daniel Varcasia14, José Simhan15, Luis Lisenfeld16 y Daniel Ekizian17.
SADEBAC: Horacio Lopardo18, Jorgelina Smayevsky19, Federico Nicola20 y Sara Kaufman21.
SAM: Manuel Klein22, Claudio Baldomir23 y Gustavo Badariotti24.
SOGIBA: Francisco Basilio25, Juan Carlos Nassif26 y César Ponce27.
1 Infectólogo, Servicio de Infectología, Hospital Durand, Buenos Aires, Argentina. 2 Infectólogo, Servicio de Infectología, Hospital Bernardo Houssay, Vicente López (Pcia. de Buenos Aires), Argentina. 3 Infectóloga, Servicio de Infectología, Sanatorio Méndez, Buenos Aires, Argentina. 4 Infectóloga, Servicio de Infectología, Hospital Italiano, Buenos Aires, Argentina. 5 Infectólogo, Servicio de Infectología, Hospital Vélez Sársfield,Buenos Aires, Argentina. 6 Infectólogo, Servicio de Infectología, Hospital HIGA Diego Paroissien, Isidro Casanova (Pcia. de Buenos Aires), Argentina. 7 Infectóloga, Fundación Centro de Estudios Infectológicos,Buenos Aires, Argentina. 8 Médica Clínica, Hospital Italiano, Buenos Aires, Argentina. 9 Infectólogo, Unidad de Enfermedades Infecciosas, Hospital Español, Rosario (Pcia. de Santa Fe), Argentina. 10 Infectólogo, Servicio de Infectología, Hospital Ramón Santamarina, Tandil (Pcia. de Buenos Aires), Argentina. 11Infectólogo, Servicio de Infectología, Hospital Carlos Bocalandro, LomaHermosa (Pcia. de Buenos Aires), Argentina. 12 Infectóloga, Servicio de Infectología, Instituto de Rehabilitación Psicofísica, Buenos Aires, Argentina. 13 Enfermera en Control de Infecciones, Servicio de Infectología, Hospital Italiano, Buenos Aires, Argentina. 14 Urólogo, Unidad de Urología, Hospital Aeronáutico Central, Buenos Aires, Argentina. 15 Urólogo, Unidad de Urología, Hospital Aeronáutico Central, Buenos Aires, Argentina. 16 Urólogo, Unidad de Urología, Hospital Aeronáutico Central, Buenos Aires, Argentina. 17Urólogo, Unidad de Urología, Hospital Israelita, Buenos Aires, Argentina. 18 Microbiólogo, Servicio de Microbiología, Hospital de Pediatría “Prof. Dr. Juan P. Garrahan”, Buenos Aires, Argentina. 19 Bioquímica, Especialista en Microbiología Clínica, Laboratorio de Microbiología, CEMIC, Buenos Aires, Argentina. 20 Microbiólogo, Laboratorios Britania, Buenos Aires, Argentina.
Correspondencia:
Dr. Gabriel Levy Hara
Av. Díaz Vélez 5044, 1406 Buenos Aires, Argen-tina.
e-mail: glevyhara@fibertel.com.ar
Definición
La bacteriuria asintomática (BA) es la presencia de un número específico de bacterias, que se estratifica según género ó presencia de dispositivo en una muestra de orina correctamente recogida, en una persona sin síntomas atribuibles a una infección urinaria.
Prevalencia
La BA es frecuente, pero su prevalencia varía ampliamente según la población en estudio (tabla 1).
Patogenia
El tracto genitourinario en sujetos normales es estéril, excepto la uretra terminal.
En las mujeres sanas, la BAaumenta en frecuencia con la edad y su presencia en la juventud está claramente asociada con la actividad sexual. A medida que aumenta la edad, algunos factores como el déficit de acción de los estrógenos en la vagina, y otros como el prolapso, aumentan la incidencia de bacteriuria (5,14).
En el caso de los pacientes diabéticos, correlaciona con la duración de la diabetes y con las complicaciones a largo plazo más que con el control metabólico de la enfermedad.
En hombres jóvenes la prevalencia es baja, pero va aumentando con la edad debido aparentemente a diversos factores como la uropatía obstructiva, la hipertrofia prostática y la pérdida de la capacidad bactericida de los fluidos prostáticos.
En los ancianos en general también hay otros factores que aumentan la prevalencia de BA, como las enfermedades neurólogicas que se asocian con vejiga neurogénica, e incontinencia intestinal, esta última en discusión como factor independiente. Los pacientes con catéteres adquieren BAa razón de 2-7 % por día, por vía exo ó endoluminal. En aquellos con daño medular, ya sea que se manejen con cateterismo intermitente o mediante condones, la prevalencia es mayor al 50%.
Finalmente, la presencia de stents se asocia con una prevalencia de bacteriuria que alcanza al 100% en aquellos colocados en forma permanente.
En los pacientes internados la bacteriuria es más frecuente que en la comunidad. En general los gérmenes involucrados tienen una mayor resistencia debido a los múltiples cursos previos de antibióticos utilizados, y a la contaminación cruzada propia de las instituciones (5).
Las bacterias suelen provenir del intestino, y no difieren de las causantes de IU. La Escherichia coli es el germen hallado con mayor frecuencia, pero las cepas aisladas de pacientes con BA tienen menos factores de virulencia que aquellas que causan IU (5,6). En los hombres también se pueden hallar con cierta frecuencia Staphylococcus coagulasa negativo y enterococo (5).
En los pacientes sondados a corto plazo, la BA suele ser causada por un solo microorganismo, siendo también el más frecuente Escherichia coli. En contraste, en pacientes portadores de sondas urinarias colocadas durante más de treinta días, la BA es polimicrobiana en el 95% de los casos, y predominan las enterobacterias (15).
Diagnóstico microbiológico
Se debe utilizar para el diagnóstico una muestra de orina tomada con la técnica correcta y que haya sido trasladada al laboratorio del modo adecuado para limitar el sobrecrecimiento bacteriano y la contaminación.
La piuria por otra parte es evidencia de inflamación, es común en los pacientes con BA (30% en mujeres jóvenes, 70% en embarazadas, 90% en ancianos internados y 50 a 100% en pacientes con catéteres de largo plazo) y su presencia no debe interpretarse como sinónimo de IU que requiere tratamiento (5).
Para el diagnóstico de BA se han establecido los siguientes puntos de corte:
Mujeres asintomáticas: dos muestras tomadas por chorro medio en las que se aísla igual germen en recuento >105 UFC/mL(5).
Hombres asintomáticos: una muestra con conteo >105 UFC/mLcon una sola especie (5).
Pacientes sondados: una muestra con conteo >102 UFC/mL(5).
Puntos prácticos
- La presencia de piuria no es criterio de tratamiento antibiótico
- La adecuada interpretación de los resultados dependerá de la calidad del material remitido –evitando la contaminación y las demoras –, del sexo del paciente y del recuento de colonias.

Manejo de la bacteriuria asintomática en circunstancias particulares
La necesidad de tratamiento en cada caso debe ser guiada por el riesgo del paciente de desarrollar complicaciones urinarias ó sistémicas a partir de la BA y de la capacidad potencial del tratamiento antibiótico de prevenir estas complicaciones y cambiar el pronóstico. Varias series publicadas demostraron que no había diferencias a largo plazo en enfermedad renal e hipertensión entre mujeres con y sin bacteriuria (16,17). Un trabajo prospectivo aleatorizado demostró que no había diferencias en los episodios de IU a largo plazo entre aquellas pacientes en las que se trataba la bacteriuria asintomática y las que recibían placebo (18). En las pacientes diabéticas, hay estudios prospectivos que no demostraron diferencias a largo plazo en incidencia de infección sintomática, complicaciones de la diabetes o mortalidad. Un estudio aleatorizado que comparó antibióticos versus placebo tampoco mostró diferencias a largo plazo de episodios sintomáticos u hospitalizaciones (3,19).
En los siguientes grupos poblacionales, la búsqueda y/ó el tratamiento de la BA, NO ha demostrado ser beneficiosa (2,3,5,7,8,9).
- Mujer joven premenopáusica (AI)
- Diabéticos (AI)
- Ancianos de la comunidad (AI)
- Ancianos provenientes de geriátricos (AI)
- Pacientes con daño medular (A II)
- Pacientes sondados a corto ó largo plazo (AI)
Por el contrario, debe realizarse la búsqueda y eventual tratamiento antibiótico de la BAen las siguientes poblaciones:
- Mujeres embarazadas (AI)
- Pacientes que serán sometidos a maniobras urológicas con sangrado mucoso como por ejemplo, cistoscopias, ureteroscopias, estudios urodinámicos, etc.) (5). En estos casos la recomendación general es realizar un urocultivo previo y poco antes de la maniobra indicar tratamiento antibiótico según antibiograma.
Los antibióticos serán suspendidos luego de realizado el procedimiento a menos de que el paciente permanezca sondado (5).
A pesar de que no se dispone de buena evidencia, este Consenso Intersociedades recomienda realizar pesquisa de BA y eventual tratamiento en pacientes que serán sometidos a cirugías limpias vasculares ó con colocación de prótesis.
En las siguientes poblaciones, la búsqueda y tratamiento de la BA no tiene una indicación precisa (5).
- Transplante renal
- Pacientes HIV positivos
- Transplante de órganos sólidos
Puntos prácticos
- La búsqueda de BA debe limitarse a aquellas poblaciones en las que está indicado el tratamiento como embarazadas, pacientes que serán sometidos a procedimientos urológicos con sangrado mucoso y pacientes que serán sometidos a cirugías vasculares o con colocación de prótesis.
Referencias Bibliográficas
1. Sobel JD, Kaye D. Urinary tract infections. Mandell, Douglas and Bennett’s. Principles and practice of Infectious Diseases 6th ed. Elsevier Churchill- Livingstone; 2005. p 875-905.
2. Andriole V. Asymptomatic bacteriuria in patients with diabetes: enemy or innocent visitor. N Engl J Med 2002;347:1617-8.
3. Harding GK, Zhanel GG, Nicolle LE, Cheang M. Manitoba Diabetes Urinary Tract Infection Study Group. Antibiotic treatment in diabetic women with asymptomatic bacteriuria N Engl J Med 2002;347:1576- 83.
4. Stamboulian D. Infección urinaria no complicada. Funcei, 1998.
5. Nicolle L, Bradley S, Colgan R, Rice J, Schaeffer A, Hooton TM. Infectious Diseases Society of America guidelines for the diagnosis and treatment of asymptomatic bacteriuria in adults. Clinical Infectious Diseases 2005;40:643-654.
6. Svanborg C, Godaly G. Bacterial virulence in urinary tract infection. Infect Dis Clin North Am 1997;11:513-30.
7. Nicolle L. Asymptomatic bacteriuria in the elderly. Infect Dis Clin North Am 1997;11:647-63.
8. Hooton TM, Scholes D, Stapleton AE, Roberts PL, Winter C, Gupta Ketal. A prospective study of asymptomatic bacteriuria in sexually active young women. N Engl J Med 2000;343:992-7.
9. Geerlings SE, Stolk RP, Camps MJ, Netten PM, Collet JT, Schneeberger PM, Hoepelman AI. Consequences of asymptomatic bacteriuria in women with diabetes. Arch Intern Med 2001;161:1421-7.
10. Boscia JA, Kobasa WD, Knight RA, Abrutyn E, Levison ME, Kaye D. Therapy versus no therapy for bacteriuria in elderly ambulatory nonhospitalized woman. JAMA 1987;257:1067-71.
11. Nordenstam GR, Brandberg CA, Oden AS, Svanborg Eden CM, Svanborg A. Bacteriuria and mortality in an elderly population. N Eng J Med 1986;314:1152-6.
12. Shortliffe LM, McCue JD. Urinary tract infection at the age extremes: pediatrics and geriatrics.Am J Med 2002;113(Suppl 1A):55S-66S.
13. Siroky MB. Pathogenesis of bacteriuria and infection in the spinal cord injured patient. Am J Med 2002;113(Suppl 1A):67S-79S.
14. Nicolle LE. Asymptomatic bacteriuria: when to screen and when to treat. Infect Dis Clin North Am 2003;17:367- 94.
15. Sanjay S, Chenoweth C. Biofilms and catheter associated urinary tract infections. Infect Dis Clin North Am 2003;17:411-32.
16. Alwall N. On controversial and open questions about the course and complications of non-obstructive urinary tract infection in adult women. Follow-up for up to 80 months of 707 participants in a population study and evaluation of a clinical series of 36 selected women with a history of urinary tract infection for up to 40 years. Acta Med Scand 1978;203:369-77.
17. Tencer J. Asymptomatic bacteriúria – a long term study. Scand J Urol Nephrol 1988;22:31-4.
18. Asscher AW, Sussman M, Waters WE et al. Asymptomatic bacteriuria in the non pregnant woman II. Response to treatment and follow up. BMJ 1969;1:804-6.
19. Semetkowska-Jurkicwicz E, Horoszec-Maziarz S et al. The clinical course of untreated asymptomatic bacteriuria in diabetic patients- 14 years of follow up. Mater Med Pol 1995;27:91-






